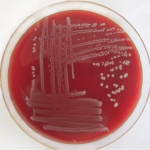
Pathogenic Drug Resistant Bacteria Found in Ukraine War Victims Klebsiella pneumoniae

Realme V60 Pro: A Budget-Friendly Phone
Realme V60 Pro: A Budget-Friendly Phone with Flagship-Grade Durability
Realme has expanded its V series with the launch of the V60 Pro, a budget-friendly smartphone...
Pathogenic Drug Resistant Bacteria Found in Ukraine War Victims
The ongoing war in Ukraine has led to not only humanitarian crises but also unexpected health challenges. Recent research from Lund University, Sweden, has...
Dry Yogurt Food Hack Goes Viral on TikTok
TikTok has given rise to countless viral food trends, and the latest one turning heads is dry yogurt. This unique snack involves removing the...
Hailee Steinfeld and Josh Allen
Hailee Steinfeld and Josh Allen: A Love Story Blossoms
In a heartwarming announcement that has captivated fans worldwide, actress and singer Hailee Steinfeld and Buffalo...
Upcoming Car Launches and Debuts in December 2024
Upcoming Car Launches and Debuts in December 2024: A Detailed Overview
December 2024 promises to be an exciting month for auto enthusiasts in India, with...
Kia Syros: A New Compact SUV Ready to Impress
Kia Syros: A New Compact SUV Ready to Impress
Kia is set to launch its newest addition to the Indian SUV market, the Kia Syros....
Maximizing Your Portable Gaming Experience
Maximizing Your Portable Gaming Experience: Advanced Battery-Saving Tips
In the realm of portable gaming, battery life is a critical factor that can significantly impact your...
Poco C75 5G: A Rebranded Redmi A4 5G
Poco C75 5G: A Rebranded Redmi A4 5G on the Horizon?
Poco is gearing up to launch yet another budget-friendly smartphone in India, the Poco...